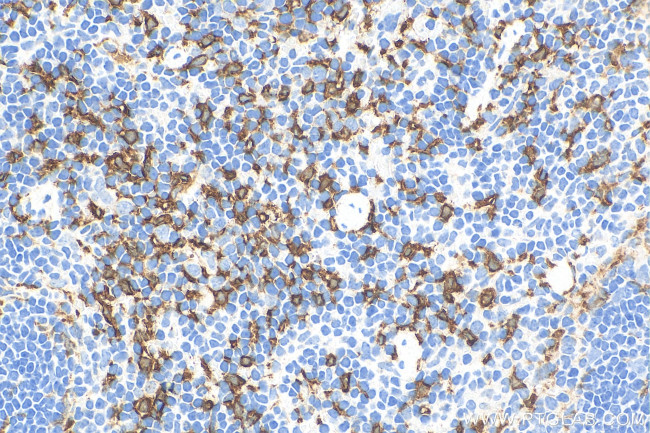
HO-1/Hmox1 Antibody in Immunohistochemistry (Paraffin) (IHC (P))

Search
Proteintech
HO-1/Hmox1 Recombinant Rabbit Monoclonal Antibody (240236G4)
{{$productOrderCtrl.translations['antibody.pdp.commerceCard.promotion.promotions']}}
{{$productOrderCtrl.translations['antibody.pdp.commerceCard.promotion.viewpromo']}}
{{$productOrderCtrl.translations['antibody.pdp.commerceCard.promotion.promocode']}}: {{promo.promoCode}} {{promo.promoTitle}} {{promo.promoDescription}}. {{$productOrderCtrl.translations['antibody.pdp.commerceCard.promotion.learnmore']}}
产品信息
83291-3-RR
种属反应
宿主/亚型
Expression System
分类
类型
克隆号
抗原
偶联物
形式
浓度
纯化类型
保存液
内含物
保存条件
运输条件
靶标信息
Heme oxygenase (HO) is a microsomal enzyme that catalyzes the oxidation of heme to the antioxidant molecules, biliverdin and carbon monoxide. HO consists of two homologous isozymes, an inducible HO-1 and a constitutively expressed HO-2. HO-1 is induced by a wide variety of stimuli including conditions of oxidative stress, inflammatory agents, transforming growth factor beta and heat shock. The increase in expression of HO-1 is thought to be a cellular defense mechanism against oxidative stress since elevated HO could eventually generate more bilirubin, an anti-oxidant.
仅用于科研。不用于诊断过程。未经明确授权不得转售。
篇参考文献 (0)
生物信息学
蛋白别名: heme orygenase 1; heme oxygenase (decycling) 1; Heme oxygenase 1; hemoxygenase; HO-1; P32 protein
基因别名: D8Wsu38e; Hemox; Hmox; Hmox1; HO-1; HO1; Hsp32
UniProt ID: (Mouse) P14901
Entrez Gene ID: (Mouse) 15368